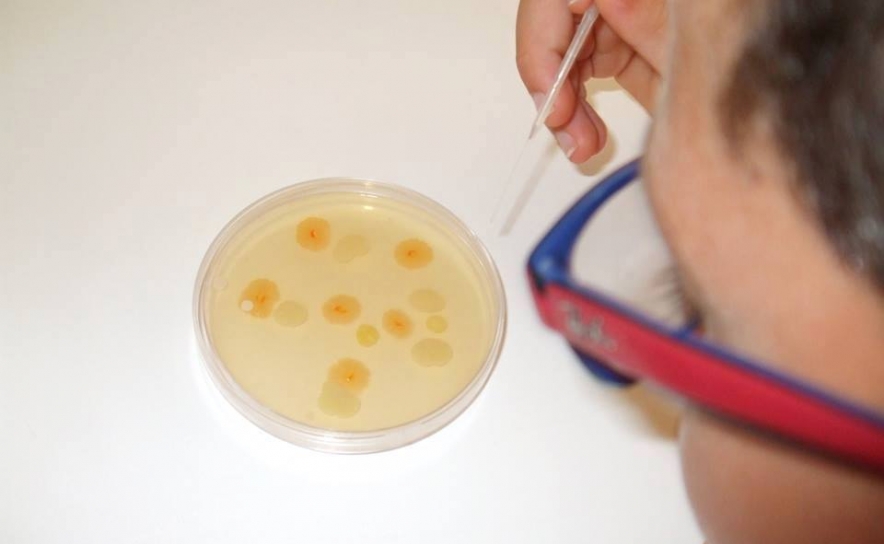

Este ano a escola já recebeu 350 crianças e jovens que visitaram e realizaram experiências no âmbito do "Centro de Ciências Experimentais" da Escola. Estão previstas ainda visitas durante o mês de setembro, nomeadamente de crianças de São Bartolomeu de Messines.
A Escola pretende contribuir para um alargamento ainda mais efetivo do Campus Académico de Silves às respetivas comunidades locais e permitir que muitos jovens tenham uma primeira experiência com a ciência, numa perspetiva prática e lúdica.
Por iPiaget